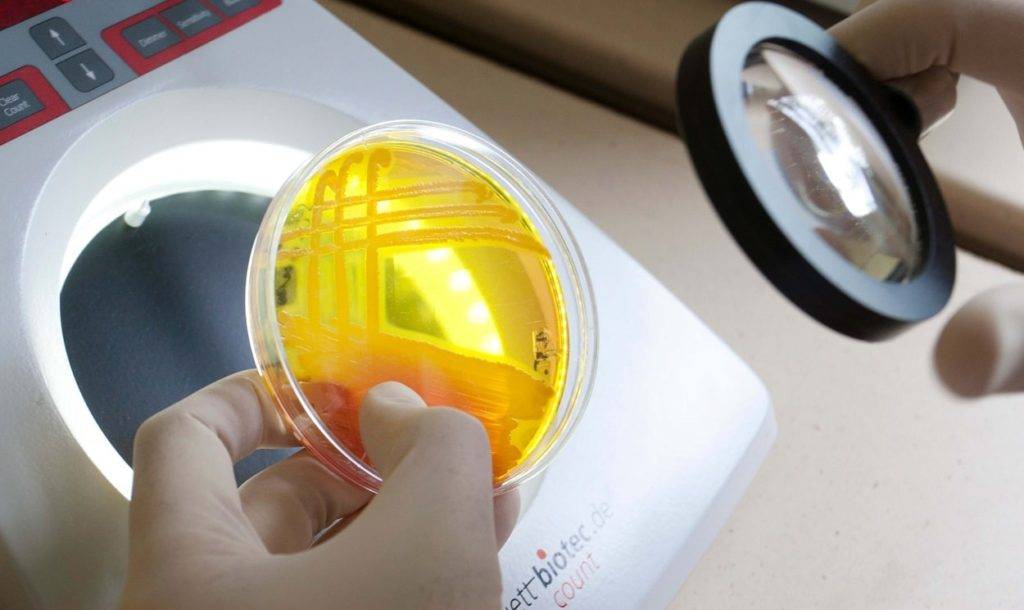

Есть ли профилактика эпиглоттита?
Педиатр Полина Кизино: «По статистике острый эпиглоттит в большинстве случаев вызывается гемофильной палочкой типа В — Haemophilus influenzae type b, сокращенно Hib или ХИБ — поэтому главная профилактика — это вакцинация от этого возбудителя».
Существуют моновакцины (АКТ-ХИБ, Хиберикс и тд), есть ХИБ-компонент в многокомпонентных вакцинах (Пентаксим, Инфанрикс Гекса). В российский нацкалендарь ХИБ-вакцина пока входит только для групп риска, поэтому родители редко знают о ее существовании.
Материалы о различных детских заболеваниях мы собираем для вас в серии статей «справочник».
Эксперты:
Полина Александровна Кизино
Другие заболевания из группы Болезни органов дыхания:
| Агенезия и Аплазия |
| Актиномикоз |
| Альвеококкоз |
| Альвеолярный протеиноз легких |
| Амебиаз |
| Артериальная легочная гипертония |
| Аскаридоз |
| Аспергиллез |
| Бензиновая пневмония |
| Бластомикоз североамериканский |
| Бронхиальная Астма |
| Бронхиальная астма у ребенка |
| Бронхиальные свищи |
| Бронхогенные кисты легкого |
| Бронхоэктатическая болезнь |
| Врожденная долевая эмфизема |
| Гамартома |
| Гидроторакс |
| Гистоплазмоз |
| Гранулематоз вегенера |
| Гуморальные формы иммунологической недостаточности |
| Добавочное легкое |
| Ехинококкоз |
| Идиопатический Гемосидероз легких |
| Идиопатический фиброзирующий альвеолит |
| Инфильтративный туберкулез легких |
| Кавернозный туберкулез легких |
| Кандидоз |
| Кандидоз легких (легочный кандидоз) |
| Кистонозная Гипоплазия |
| Кокцидиоилоз |
| Комбинированные формы иммунологической недостаточности |
| Кониотуберкулез |
| Криптококкоз |
| Ларингит |
| Легочный эозинофильный инфильтрат |
| Лейомиоматоз |
| Муковисцидоз |
| Мукороз |
| Нокардиоз (атипичный актиномикоз) |
| Обратное расположение легких |
| остеопластическая трахеобронхопатия |
| Острая пневмония |
| Острые респираторные заболевания |
| Острый абсцесс и гангрена легких |
| Острый бронхит |
| Острый милиарный туберкулез легких |
| Острый назофарингит (насморк) |
| Острый обструктивный ларингит (круп) |
| Острый тонзиллит (ангина) |
| Очаговый туберкулез легких |
| Парагонимоз |
| Первичный бронхолегочный амилоидоз |
| Первичный туберкулезный комплекс |
| Плевриты |
| Пневмокониозы |
| Пневмосклероз |
| Пневмоцитоз |
| Подострый диссеминированный туберкулез легких |
| поражение газами промышленного происхождения |
| Поражение легких вследствие побочного действия лекарственных препаратов |
| поражение легких при диффузных болезнях соединительной ткани |
| Поражение легких при болезнях крови |
| Поражение легких при гистиоцитозе |
| Поражение легких при дефеците а 1- антитрипсина |
| поражение легких при лимфогранулематозе |
| Поражение легких при синдроме марфана |
| Поражение легких при синдроме Стивенса-Джононса |
| Поражения легких отравляющими веществами |
| Пороки развития легких |
| Простая Гипоплазия |
| Радиационные поражения легких |
| Рецидивирующий бронхит у детей |
| Саркаидоз органов дыхания |
| Секвестрация легкого |
| Синдром гудпасчера |
| Синдром Маклеода |
| Синдром Мендельсона |
| Синусит |
| Спонтанный пневмоторакс |
| Споротрихоз |
| Стафилококковые деструкции легких у детей |
| Стенозы и трахеи крупных бронхов |
| Стенозы и трахеи крупных бронхов |
| Стрептококковый фарингит |
| Сфеноидальный синусит (сфеноидит) |
| Токсоплазмоз |
| Трахеальный бронх |
| Трахеит |
| Трахеобронхомегалия |
| Тромбоэмболия легочной артерии (ТЭЛА) |
| Туберкулез внутригрудных лимфатических узлов (бронхоадениты) |
| Туберкулез бронхов, трахеи, верхних дыхательных путей |
| Туберкулез гортани |
| Туберкулез легких |
| Туберкулез полости рта, миндалин и языка |
| Туберкулезная интоксикация у детей и подростков |
| Туберкулезный плеврит |
| Туберкулема легких |
| Фарингит |
| Фиброзно-кавернозный туберкулез |
| Фронтит (острый фронтальный синусит) |
| Хроническая пневмония |
| Хроническая пневмония у детей |
| Хронический абсцесс легких |
| Хронический бронхит |
| Хронический гематогенно-диссеминированный туберкулез легких |
| Хроническое легочное сердце |
| Цирротический туберкулез легких |
| Шистосомозы |
| Экзогенный аллергический альвеолит |
| Эмфизема легких |
| Этмоидальный синусит (этмоидит) |
Диагностика
Осмотр и анамнез
Наблюдая малыша с воспалением надгортанника, врач обращает внимание на жалобы и поведение ребёнка. Доктор расспрашивает родителей, когда появились первые симптомы и как менялись клинические проявления болезни
Нередко предъявляемые жалобы и тяжесть состояния крохи указывают на развитие тонзиллита, но при осмотре глотки малыша признаков воспаления миндалин не обнаруживается.
Несоответствие клинических проявлений недуга и картины в гортаноглотке является одним из частых признаков эпиглоттита. При воспалении надгортанника врач обнаружит лишь гиперемию слизистой оболочки и увеличение слюнообразования.

Клинический анализ крови
В гемограмме обнаруживаются признаки воспаления, вызванного бактериальным инфекционным агентом – повышение количества лимфоцитов со сдвигом формулы влево (преобладание юных форм). Лейкопения — снижение числа белых клеток крови, встречается реже и говорит об истощении защитных сил организма.
Инструментальная диагностика
С помощью специальных приборов можно увидеть надгортанник и удостовериться в правильности диагноза. Наилучшим методом исследование считается введение гибкого эндоскопа (фиброринофаринголарингоскопа) и определение степени поражения надгортанника. В случаях отсутствия специального прибора возможно проведение прямой ларингоскопии, отодвигание корня языка в сторону и рассмотрение входа в гортань.
Бактериологический посев
С помощью данного метода можно не только выявить возбудителя, вызвавшего заболевание, но и определить чувствительность бактерии к различным антибиотикам. К сожалению, для выращивания колоний микроорганизмов на питательной среде необходимо некоторое время. Поскольку состояние крохи может ухудшиться в любую минуту, противомикробные препараты выбирают исходя из данных о самом распространённом возбудителе (Haemophilus influenzae).
Диагностика
При возникновении подозрения на эпиглоттит необходимо немедленно вызывать скорую помощь и обеспечить реанимационные условия. Для постановки диагноза обязательно записаться на прием отоларинголога, иногда требуется консультация педиатра.
Исследование должно проводиться максимально осторожно, поскольку любые манипуляции могут привести к полному закрытию оставшегося просвета. Как правило, применяются инструментальные методы диагностики – фарингоскопия, ларингоскопия
Врач может заметить разрастание эпиглоттиса, его малую подвижность, отек, разбухание сосудов на органе. Если заболевание демонстрирует абсцедирующую форму, то в очаге воспаления можно обнаружить гнойник.
К лабораторным методам анализа относятся мазок на флору, анализ крови для выявления бактерий.
Для подтверждения диагноза выполняется рентген шеи, который демонстрирует увеличенные очертания воспаленного органа.
Симптомы коронавируса у детей
По данным научно-исследовательской базы PubMed, коронавирус у детей проявляется следующими симптомами:*
- Лихорадка и высокая температура (64% больных);
- Кашель (35%);
- Ринорея (16%);
- Расстройства ЖКТ: понос, рвота, диарея, метеоризм (12%).
Последствия коронавируса у детей по результатам лабораторной диагностики:
- Лимфопения (33%);
- Повышение уровня D-димера (52%);
- Повышение уровня С-реактивного белка (40%).
Специфические признаки коронавируса у детей разных возрастных групп:
1. У детей 0-12 месяцев:
- «Ковидные пальцы» — воспаления, локализованные в области конечностей (пальцев рук и ног), напоминают легкое обморожение;
- Раздувание крыльев носа — происходит на фоне нарушения дыхания, появления хрипов;
- Ребенок заметно устает во время грудного вскармливания, отказывается от материнского молока.
2. У детей от 1 года до 8 лет:
У детей из этой возрастной группы чаще наблюдается ринит и пневмония — выраженные симптомы острого респираторного заболевания разной степени тяжести. Наиболее распространенным радиологическим признаком воспаления легких на КТ у детей является симптом «матового стекла».
3. У детей от 8 до 12 лет:
Признаки коронавируса практически идентичны заболеванию у взрослого человека.
Чтобы оценить выраженность симптомов коронавируса у маленьких детей, обратимся к сравнительному исследованию группы китайских врачей.* Были изучены истории болезней 9 детей младенческого возраста (лабораторные анализы, данные КТ легких) и членов их семей, поступивших в больницу. Примечательно, что взрослые были сильно больны: в 57,1% случаев отмечена тяжелая лихорадка, в 71,4% случаев — патологические изменения в легких (вирусная пневмония), в 50% случаев — лимфоцитопения. Между тем только у 3 маленьких пациентов были симптомы лихорадки (22,2%) или кашля (11,2%), а у 6 детей (66,7%) никаких симптомов не было.

Течение COVID-19 у детей
Женщина с заболевшим ребенком. Фото: prostooleh / freepik.com
Дети болеют COVID-19 значительно реже, чем взрослые, а клинические проявления у них менее выражены. Основными симптомами у детей являются (рис. 3):
- повышение температуры тела,
- сухой кашель,
- незначительная боль в мышцах,
- общая слабость.
Также наблюдаются характерные изменения вкуса и утрата обоняния.
В отличие от взрослых, у детей чаще встречаются расстройства желудочно-кишечного тракта в виде диареи, боли в животе, тошноты и рвоты. При этом нарушения работы ЖКТ в сочетании с лихорадкой у них часто являются единственными клиническими проявлениями коронавирусной болезни.
У детей на фоне инфицирования SARS-CoV-2 может развиваться мультисистемный воспалительный синдром, который считается аналогом «цитокинового шторма» у взрослых. Клинически он проявляется периодически возникающим повышением температуры тела до 38℃ и воспалительным поражением внутренних органов и систем, в том числе — дыхательной и сердечно-сосудистой систем, желудочно-кишечного тракта, почек, нервной системы, кожных покровов. В тяжелых случаях у детей наблюдают сепсис и полиорганную недостаточность, приводящие к смерти.
Что делать, если появились симптомы COVID-19?
При подозрении на развитие COVID-19, например — при контакте с больным человеком, необходимо придерживаться следующего порядка действий:
- Обратиться к семейному доктору или в поликлинику по телефону. Тщательно следовать всем предписаниям специалистов.
- Постараться самоизолироваться в отдельной комнате на срок не менее 14 дней, даже при условии отсутствия симптомов COVID-19. В противном случае соблюдать дистанцию не менее 1 метра с близкими, используя все средства индивидуальной защиты — медицинскую маску, перчатки, антисептики.
- Придерживаться постельного режима и употреблять большое количество теплой жидкости, например — чая.
- Исключить любой контакт с детьми, пожилыми людьми и членами семьи с хроническими заболеваниями.
Заключение
Учитывая все еще неполное понимание COVID-19 учеными и медиками, стоит прислушиваться к своему телу и обращать внимание на все изменения, которые в нем происходят. Несмотря на то, что в большинстве случаев коронавирусная инфекция сопровождается довольно характерными клиническими признаками, например — утратой обоняния и вкуса, заболевание также может протекать в стертой или бессимптомной форме
Нужно быть внимательным и при первых подозрениях обратиться за консультацией к специалисту.
Редкие симптомы
Сравнительно редко при COVID-19 наблюдают расстройства психики. Как правило, они встречаются среди лиц старшего возраста, а также у людей с заболеваниями центральной нервной системы. Чаще всего это:
- раздражительность,
- бессонница,
- спутанность сознания,
- необоснованное, чрезмерное беспокойство,
- депрессия.
Также встречаются более тяжелые и редкие неврологические осложнения:
- судорожные припадки,
- нарушения мозгового кровообращения,
- повреждение периферических нервов (нейропатии).
В некоторых случаях, на фоне заболеваний зубов, десен или неправильного прикуса, COVID-19 способствует осложнениям в виде:
- истончения зубной эмали, ее разрушения,
- грибковых инфекций ротовой полости и даже потери зубов.
4.Лечение
Учитывая вышесказанное, остается только повторить: эпиглоттит относится к неотложным жизнеопасным состояниям, и при первых признаках «Скорая помощь» должна быть вызвана немедленно. У маленьких детей эпиглоттит нередко начинается внезапно, в вечернее или ночное время, когда ребенок уже уснул – и просыпается с высокой температурой и затрудненным дыханием; от быстрой адекватной реакции родителей в данной ситуации зависит очень многое. В отсутствие медицинской помощи полная блокировка дыхательных путей при эпиглоттите может наступить уже через 2-5 часов с момента появления первых симптомов.
Текст подготовил

Котов Максим Анатольевич, главный врач центра КТ «Ами», кандидат медицинских наук, доцент. Стаж 19 лет
Список источников
- Котов М.А. Опыт применения компьютерной томографии в диагностике заболеваний органов дыхания у детей / Материалы X Невского радиологического Форума (НРФ-2018). – СПб., 2018, Лучевая диагностика и терапия. 2018. № 1 (9). — С. 149.
- Панов А.А. Пневмония: классификация, этиология, клиника, диагностика, лечение, 2020.
- Бова А.А. Пневмонии: этиология, патогенез, клиника, диагностика, 2016.
- Chl Hong, M.M Aung , K. Kanagasabai , C.A. Lim , S. Liang , K.S Tan. The association between oral health status and respiratory pathogen colonization with pneumonia risk in institutionalized adults, 2018.
- Yang-Pei Chang, Chih-Jen Yang, Kai-Fang Hu, A-Ching Chao, Yu-Han Chang, Kun-Pin Hsieh, Jui-Hsiu Tsai, Pei-Shan Ho, Shen-Yang Lim. Risk factors for pneumonia among patients with Parkinson’s disease: a Taiwan nationwide population-based study, 2016.
- Клинические рекомендации по диагностике, лечению и профилактике тяжелой внебольничной пневмонии у взрослых. Министерство здравоохранения РФ, 2019.
Признаки болезни

При эпиглоттите у детей симптомы проявляются:
- болевыми ощущениями, першением и сухостью в горле;
- обильным слюнотечением;
- дисфонией — охриплостью, осиплостью и гнусавостью голоса;
- дисфагией — нарушением глотательной функции;
- афонией — потерей звучности голоса, из-за чего ребенок переходит на шепот;
- затруднением дыхания;
- стридором — шумным свистящим дыханием;
- синюшностью губ;
- повышенной температурой (38–39⁰);
- тревожностью и беспокойством.
По мере увеличения стеноза гортани появляется одышка, развиваются цианоз и тахикардия. Чтобы облегчить состояние, малыш занимает вынужденное положение, получившее название «позы треножника»: он садится, максимально разгибает позвоночник и наклоняется вперед, вытягивает шею, широко открывает рот и высовывает язык, при вдохе раздувает ноздри.
В зависимости от выраженности симптоматики выделяют 3 формы эпиглоттита: инфильтративную, отечную и абсцедирующую. При абсцедирующей форме возможны абсцесс, флегмона, эмпиема плевры, медиастинит.
Болезнь развивается стремительно: уже через 4–6 часов наблюдается полная обструкция (непроходимость) респираторных путей и дыхательная недостаточность, что приводит к нехватке кислорода, судорогам, потере сознания и становится причиной смерти ребенка.
Записаться на прием к врачу вы можете по телефону
или с помощью системы онлайн-записи на сайте
Записаться к врачу
Прогноз
При отсутствии лечения летальный исход наблюдается в 30–40% случаев. Если предоставить своевременную медицинскую помощь, то этот показатель понижается до 1%.
Методы лечения

При эпиглоттите требуется неотложная медицинская помощь, которая предоставляется в условиях стационара, в отделении интенсивной терапии и реанимации. Транспортировать ребенка следует только в сидячем положении. Не стоит пытаться лечить болезнь самостоятельно, чтобы избежать смертельного исхода.
Если диагностирован эпиглоттит у детей, лечение направлено на восстановление проходимости дыхательных путей. С этой целью мы назначаем антибиотикотерапию, симптоматическую и инфузионную терапию, включающую прием седативных и дезинтоксикационных средств, спазмолитиков, внутривенное введение иммуноглобулина, физраствора и питательных препаратов, ингаляции глюкокортикостероидов, постановку компрессов с димексидом.
Если консервативное лечение не оказывает нужного результата, мы прибегаем к хирургическому вмешательству:
- трахеотомии — в дыхательные пути ребенка вводим пластиковую трубку, обеспечивающую свободное дыхание;
- интубации трахеи — с помощью особой трубки расширяем дыхательный просвет.
При инфильтративном эпиглоттите в наиболее отечных зонах мы делаем насечки на надгортаннике. Если наблюдается абсцесс, то мы его вскрываем.
Почему развивается
Впервые понятие неврастении ввел американский врач Георг Бирд в 1869 году. Затем случаи заболевания были выявлены в Германии и Франции. В России о расстройстве узнали в 1899 году. В то время оно описывалось как состояние периодической усталости в юношеском возрасте. Постепенно признаки неврастении ограничили более узкими рамками.
Главной причиной расстройства становится стресс и переутомление. Стресс может быть:
- одномоментным, но высокой интенсивности – смерть близкого человека, потеря работы, развод.
- систематическим, но меньшей интенсивности, например, уход за тяжелым больным, психологический прессинг со стороны начальника и другие повторяющиеся конфликты, неспособность найти выход из сложившейся ситуации.
Особая роль отводится переутомлению, как физическому, так и умственному, а также дефициту сна и эмоциональному напряжению.
Важным звеном является способ мышления человека, манера поведения и сложившаяся система ценностей, поскольку нередко нервное напряжение, переживания возникают на фоне идущих вразрез потребностей и возможностей больного с реалиями действительности. Однако в данной ситуации стоит учитывать уровень адаптивности к изменяющимся условиям, ведь каждый человек реагирует на одно и то же обстоятельство по-разному: кто-то справляется легко, практически без усилий, другой испытывает большие сложности и напряжение.
Таким образом, причиной неврастении становятся состояния, приводящие к дисгармонии нервной системы, нарушающие баланс между процессами возбуждения и торможения, вызывающие ее истощение.
Ведущая роль принадлежит профессиональному стрессу, сформированному тремя факторами: большой объем важной информации, обязательный к усвоению, нехватка времени, высокие амбиции. Подобная ситуация характерна для людей, занимающих руководящие должности, требующие высокой ответственности, или трудовая деятельность которых проходит в условиях конкуренции
Такой вид неврастении известен под различными названиями: информационный, экспериментальный невроз; синдром менеджера, белых воротничков.
Помимо основных причин, существуют и предрасполагающие факторы:
- инфекции;
- тяжелые, истощающие хронические заболевания;
- интоксикации;
- эндокринные заболевания;
- нарушение распорядка дня – недостаточный отдых;
- недоедание, авитаминоз;
- вредные привычки– алкоголь, курение, наркотики;
- черепно-мозговая травма;
- заболевания головного мозга – опухоли, нейроинфекции;
- внутричерепная гипертензия.
Астеническому неврозу нередко подвергаются люди с астенической конституцией (худощавость, тонкие удлиненные конечности, узкие плечи и грудная клетка). Они характеризуются быстрой утомляемостью и неспособностью переносить длительные интенсивные нагрузки, сниженным психическим тонусом и физической слабостью.
2.Причины
Гемофильная палочка b высевается при детских эпиглоттитах в 90% случаев. Однако это не единственный возможный возбудитель острого воспаления надгортанника: патогеном в разных случаях оказываются также гноеродные стрептококки, стафилококки, клебсиеллы, псевдомонады, вирусы. При глубоком иммунодефиците возможен эпиглоттит грибковой (кандидозной) этиологии.
Вообще, ослабленный иммунитет является наиболее значимым фактором риска: эпиглоттит часто вспыхивает у лиц, страдающих анемией, перенесших термическую травму или механическую травму гортани; у пациентов с тяжелыми хроническими заболеваниями, удаленной селезенкой или иммунопатологическими расстройствами.
Инфекция распространяется только от человека к человеку – воздушно-капельным путем.
Согласно различным источникам, одним из факторов риска выступает мужской пол: мальчики заболевают эпиглоттитом от полутора до двух раз чаще девочек.
Что провоцирует / Причины Эпиглоттита:
Наиболее частой причиной воспаления надгортанника является бактерия гемофилус инфлюэнце (Haemophilus influenzae), тип b. Этот вид бактерии также вызывает пневмонию и менингит. Данный микроб может попасть в дыхательные пути воздушно-капельным путем. Кроме того, гемофилус инфлюэнце может «дремать» в носовой полости до тех пор, пока неблагоприятные условия не послужат толчком для развития.
Кроме указанной бактерии к возбудителям эпиглоттита относятся также:
– Пневмококк, наиболее частый возбудитель менингита.
– Стрептококки группы А, В и С.
– Дрожжеподобный грибок кандида, возбудитель молочницы.
– Варицелла зостер – возбудитель ветряной оспы.
Эпиглоттит может возникнуть вследствие прямой травмы. Кроме того, эпиглоттит возникает вследствие ожога дыхательных путей или при употреблении очень горячих жидкостей.
Другие причины воспаления надгортанника: oжог горла химическими веществами (кислотами или щелочами), травма инородным телом, курение таких веществ, как кокаин или героин.
В 20 веке большинство случаев эпиглоттита встречалось у детей, особенно в возрасте от 2 до 7 лет. Однако вследствие повсеместной иммунизации детей, которая началась в 1985 году, число случаев эпиглоттита у детей резко снизилось. В настоящее время случай эпиглоттита встречается у одного взрослого на 100 тысяч ежегодно. У детей еще меньше.
На протяжении всего 20-ого столетия, эпиглоттит был обычной болезнью у детей особенно в возрасте от 2 до 7 лет и реже у взрослых. Но с того момента, как начали делать младенческие вакцинации в 1985, число детей с эпиглоттитом сильно понизилось. Сегодня эта болезнь встречается один раз на 100 000 взрослых и ещё реже у детей.
К возможным факторам риска эпиглоттита относятся:
– Пол. Эпиглоттит затрагивает больше мужчин чем женщин.
– Расовая принадлежность. Люди с тёмной кожей более подвержены заражению, нежели люди с белой кожей. Различные возможности медицинского обслуживания, включая вакцинации в детстве, которые не всегда доступны в менее богатых слоях населения.
– Фактор переполненных городов. Бактерии распространяются быстро, когда люди находятся в тесном контакте. Инфекции очень быстро распространяются в детских садах и яслях, но они также распространяются быстро и в школах, в офисах и в пределах домашних хозяйств.
– Слабая иммунная система. Если ваша иммунная система была ослаблена болезнью или лечением, Вы более склонны к восприятию вирусов и бактерий, которые могут вызвать эпиглоттит.





































